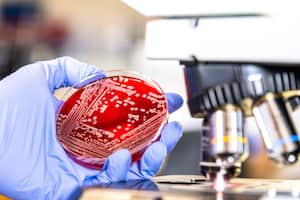
Septicemia

Salud
Cáncer de mama triple negativo, ¿uno de los más comunes en mujeres jóvenes? Experto responde
Este tipo de cáncer es considerado como uno de los más agresivos porque puede extenderse más rápido que otros.
Sígale el pulso a la salud en Discover: información sobre bienestar, investigación y tendencias

El cáncer de mama es un tipo de cáncer que se forma en las células de las mamas y se puede presentar tanto en hombres como en mujeres, sin embargo, es mucho más común en el género femenino, explica el sitio especializado Mayo Clinic, donde también se resalta que no todos los tipos de cáncer de mama son iguales y por eso es tan importante trabajar en la concientización sobre esta delicada enfermedad que puede llegar a ser mortal.
Aunque por fortuna las tasas de supervivencia al cáncer de mama han aumentado en los últimos años por los avances de las investigaciones respecto a su diagnóstico y tratamiento, los expertos indican que para lograr tener resultados favorables en quien lo padece es vital asistir al médico con regularidad para realizar una detección temprana y, de este modo, poder reaccionar a tiempo.
En este sentido, una vez se da un diagnóstico de cáncer de mama, el especialista empieza a revisar el informe patológico del paciente y los resultados de los exámenes solicitados con la intención de comprender en detalle el tumor al que se está enfrentando y decidir las diversas opciones de tratamiento según el caso.
Entre los tipos de cáncer de mama más comunes se encuentra el carcinoma ductal infiltrante, cuyas células cancerosas se originan en los conductos y después salen de ellos y se multiplican en otros tejidos mamarios, llegando a formar metástasis en otras partes del cuerpo, indica el portal de Centros para el Control y la Prevención de Enfermedades de Estados Unidos (CDC).

También está el carcinoma lobulillar infiltrante, en el que las células cancerosas se originan en los lobulillos y después se esparcen en otros tejidos mamarios cercanos provocando serias complicaciones y otros en los que existe un subtipo llamado cáncer de mama triple negativo (TNBC), que según explica el economista de la salud, Thomas Hofmarcher, en el Swedish Institute for Health Economics (IHE), suelen padecerlo en su mayoría mujeres que tienen alrededor de 50 años, aunque no se descarta la posibilidad de que aparezca en mujeres de 25 años.

¿Qué es el cáncer de mama triple negativo?
De acuerdo con los CDC, el cáncer de mama triple negativo es un tipo de cáncer que no tiene ninguno de los tres receptores que por lo general se encuentra en este tipo de tumor, es decir, (ER o PR) de estrógeno ni de progesterona (ER o PR), lo que a su vez genera que tampoco se produzca la proteína llamada factor de crecimiento epidérmico humano HER2

Debido a esto, se considera como el subtipo de cáncer de mama más agresivo porque no solo se expande más rápido que otros, sino que por sus características hay menos tratamientos para atenderlos, esto a causa de que son más comunes los tumores de mama donde exista la presencia de alguno de los tres receptores mencionados anteriormente.
Por esta razón, la American Cancer Society señala que el cáncer de seno triple negativo (TNBC) representa alrededor del 10% al 15% de todos los cánceres de seno, cuyos síntomas pueden ser los mismos que otros tipos de cáncer, como encontrar una masa o bulto extraño de manera repentina, hinchazón, formación de hoyuelos en la piel, dolor, retracción de los pezones, piel seca, descamada o gruesa, secreción irregular o ganglios linfáticos hinchados.
Sobre su tratamiento se conoce que en la mayoría de países de Latinoamérica ya están aprobados y un ejemplo claro de ello es la inmunoterapia, un tipo de tratamiento del cáncer que ayuda al sistema inmunitario a combatirlo, resalta el Instituto Nacional del Cáncer de EE. UU.